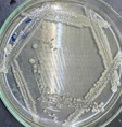

1. Phân loại nguồn gen: VI
KHUẨN
2. Tên khoa học nguồn gen: Bacillus filamentosusKT 16
3. Ký hiệu nguồn gen: VACC 634
4. Lịch sử nguồn gen:
Nơi chuyển/phân lập:
Phân lập Đất trồng sầu riêng tại Châu Thành, BếnTre
Ngày nhận: 05/12/2021
5. Hoạt tính sinh học nguồn gen:
Sinh hoạtchất KTST thựcvật:
hàmlượng IAA:
Khả năng chịu mặn: 15% NaCl
6. Điều kiện nuôi cấy:
Môi trường: Môi
trường SPA, King B
Nhiệt độ: 30 -35oC
pH: 7,0 -7,5
Thời gian nuôi cấy: 48 giờ

0 nhận xét :
Đăng nhận xét